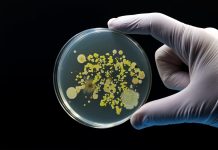
Combatting AMR: The potential of Bdellovibrio bacteriovorus as a ‘living antibiotic’ AMR

Innovation News Network brings you the latest research and innovation news from the fields of science, environment, energy, critical raw materials, technology, and electric vehicles.
Animal health as a sustainability driver for Europe’s food system
AnimalhealthEurope examines how investments in animal health drive sustainability, strengthen food security, and support a greener planet.
Making the grade on AI adoption
Trent University Durham GTA is putting people at the centre of Canada’s artificial intelligence future one breakthrough at a time.
‘Forever chemicals’ no more: How ECT is turning up the heat on PFAS remediation
ECT’s Rapid Electrothermal Mineralisation technology could deliver one of the first scalable solutions for complete PFAS destruction.
Scaling Europe’s hydrogen refuelling infrastructure: Inside the H2REF-DEMO project
H2REF-DEMO will test its hydrogen compression technology for the delivery of reliable hydrogen refuelling systems for heavy-duty vehicles.
Fermilab and Proficio launch water treatment system to combat PFAS
Fermilab and Proficio Consultancy develop water treatment system to safely eliminate PFAS contamination using electron beam technology.
Hypothiocyanite: The rise of a promising one-health molecule
Richard Stead, CEO of Qures Group, discusses the century-long history of Hypothiocyanite and the Lactoperoxidase System.
IonQ activates Slovakia’s first national quantum communication network
Discover how Slovakia’s first national quantum communication network strengthens cybersecurity and advances Europe’s quantum technology.
Reframing space debris as a resource
EIC's Stela Tkatchova explains how we can not only remove space debris but also consider space debris as a resource and learn to utilise it.
Combatting AMR: The potential of Bdellovibrio bacteriovorus as a ‘living antibiotic’
Simona Huwiler discusses the potential of Bdellovibrio bacteriovorus, a predatory bacterium, to address the growing concern of AMR.
Pioneering the future of PFAS destruction
From innovation to implementation, PFASuiki is pioneering a new approach to eliminating ‘forever chemicals’. Find out more.